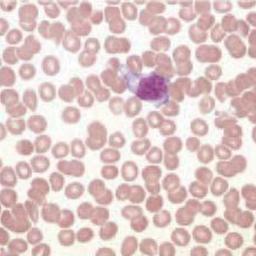
placeholder image to represent content

What are the abnormalities of red blood cells? Let's get to know them better.
Quiz by Baimas141299
Tag the questions with any skills you have. Your dashboard will track each student's mastery of each skill.
1.เม็ดเลือดแดงตัวอ่อนที่มีขนาดเซลล์ที่ใหญ่ พบนิวเคลียสกลมเกือบเต็มเซลล์ โครมาตินหยาบเล็กน้อยย้อมติดสีม่วงแดงพบ perinuclear halo และ มี Nucleoli 1-3 อัน ตรงกับเม็ดเลือดแดงตัวอ่อนชนิดใด?
2.Orthochromatic normoblast ถ้าพบเจอใน Blood smear สามารถเรียกอีกอย่างได้ว่าอะไร?
3.Basophilic stippling ต้องรายงานแบบใด ?

4.จงแปลผล CBC ของคนไข้รายนี้

5.ข้อใดกล่าวผิดเกี่ยวกับ red blood cell ?
6.ข้อใดสอดคล้องกับภาพต่อไปนี้มากที่สุด

7.ข้อใดกล่าวผิดเกี่ยวกับเซลล์ข้างต้น

8.ผู้ป่วยที่เป็น Hb H disease จุดเด่นใน blood smear จะพบอะไรได้บ้าง ?
9.ข้อใดไม่สอดคล้องกับภาพดังกล่าว

จงจับคู่เม็ดเลือดแดงชนิดต่างๆกับคำอธิบายให้ถูกต้อง ?
10.พัฒนาต่อมาจาก Proeryhthroblast มี Cytoplasm สีน้ำเงินเข้มมากขึ้น มีนิวเคลียสที่กลมอยู่กลางเซลล์ chromatin หยาบมากขึ้นจับเป็นกลุ่มเล็กที่เริ่มจะจับตัวเป็นก้อนติดสีม่วงแดง พบเห็น parachromatin และ พบ Nucleoli 0-1 อัน
11.เม็ดเลือดแดงที่สามารถนำนิวเคลียสออกไปนอกเซลล์ได้ แต่ยังคงหลงเหลือ RNA อยู่จึงทำให้เห็นสีชมพูปนม่วง เมื่อย้อมด้วย vital dye เช่น methylene blue จะเห็น RNA จับกันเป็นร่างแห
12..เม็ดเลือดแดงที่มีขนาดเล็กที่สุดในกระบวนการ Erythrocytic maturation พบ central pallor มีขนาด 1/3 ของเซลล์ที่บริเวณใจกลางเซลล์
13.เม็ดเลือดแดงตัวอ่อนที่มีขนาดเซลล์ใกล้เคียงกับเม็ดเลือดแดงตัวแก่ Cytoplasm มีสีใกล้เคียงกับ Erythrocytes นิวเคลียสมีขนาดเล็กลงมีความกลมมากอยู่ชิดด้านหนึ่งของเซลล์ มี Chromatin ที่หยาบมากและรวมเป็นเนื้อเดียวกัน
14.เม็ดเลือดแดงตัวอ่อนที่มีพื้นที่ของ cytoplasm ที่มากกว่าเดิมเล็กน้อยมีสีน้ำเงินปนแดงหรือสีม่วงอ่อน ๆ ของ hemoglobin มีการพัฒนานิวเคลียสให้กลมมากขึ้นและยึดอยู่กับด้านหนึ่งของเซลล์ chromatin หยาบเป็นก้อนและไม่พบ nucleoli
15.Committed progenitor cell ของ สายเม็ดเลือดแดงคืออะไร ?